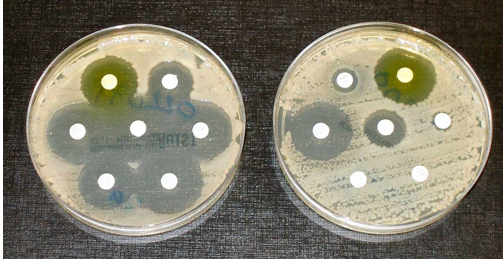
<p>Sensitivity </p>
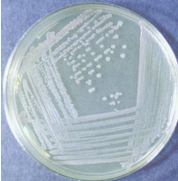
<p>Aims of bacterial culture&nbsp;</p>
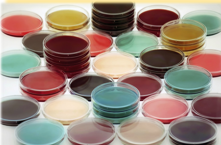
<p>Bacteria culture - Solid (jelly) nutrient solutions </p>
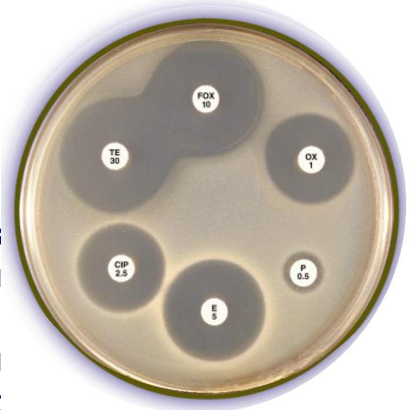
<p>Sensitivity Testing - Disc agar infusion method&nbsp;</p>

Bacteriology and Sensitivity
1/50
There's no tags or description
Looks like no tags are added yet.
Name | Mastery | Learn | Test | Matching | Spaced |
|---|
No study sessions yet.
51 Terms
Prokaryote
Single cell microbe with a simple cell structure
Most bacteria are vital for animal life (commensal) with very few being ..
Parasite or pathogens that cause disease
Commensal bacteria can become ..
Pathogenic
Prokaryotic cells contain no nucleus, this allows these cells to ..
Reproduce, very rapidly, by binary fission (cytokinesis) and require a suitable environment to live and reproduce
General requirements for life include ..
Water
Essential nutrients (species dependant)
Correct pH
Correct temperature
Some bacteria can form endospore that are ..
Dormant and resistant to hostile environmental conditions (hot, cold, radiation, disinfection etc..)
An example of an endospore producing bacteria ..
Bacillus anthracis (anthrax)
Bacillus anthracis (anthrax) - transmission
This bacteria can lie dormant in the environment(soil) for many years
Transmitted via inhalation, entry via an open wound or ingestion
It targets the gastrointestinal tract, skin and/or lungs
Particularly high risk to farm and wild animals

Bacteria are grouped into three categories based on their response to gaseous exchange
Obligate aerobes
Obligate anaerobes
Facultative anaerobes
Obligate aerobes
Requires oxygen
Obligate anaerobes
Does not require oxygen
Facultative anaerobes
Both (adaptable) (requires oxygen + doesn’t require oxygen)
Aerobic bacteria can only survive in the presence of oxygen, an example of this is ..
Leptospira spp.
Anaerobic bacteria can only survive and reproduce in areas where oxygen is not present or available, for example in the gastrointestinal tract, for example ..
Clostridium perfringens
Facultative bacteria are adaptable and can survive in environments both with or without oxygen present, for example
MRSA

Culture
Growing bacteria in a controlled laboratory environment, often by providing a nutrient-rich medium to support growth
Sensitivity
The susceptibility of bacteria to a specific antibiotic
Why would a Veterinary Surgeon choose to conduct bacterial culture and sensitivity testing?
To enable the cultivation of bacteria from a sample collected from a patient (for example, from the urine, skin, faeces etc..)
To ensure the identification of the cause of infection and/or antibiotic sensitivity test, ensuring the most appropriate antibiotic is selected for treatment. Reducing the risk of antibiotic resistance
Why would a Veterinary Surgeon choose to conduct bacterial culture and sensitivity testing - simple version
Disease diagnosis
Treatment management
Antimicrobial selection - what type of antibiotic to prescribe due to the bacteria
Prevent antimicrobial resistance
Environmental surveillance
Postmortem

Sampling and collection - Fluids
Blood
CSF
Synovial fluid
Exudates
Semen
Sputum etc..
Sampling and collection - Swabs
Ear
Skin
Wounds
Abscess
Mucosa
Tracts/stomas etc ..
Sampling and collection - other
Infection control surveillance
Prepping for taking a swab sample
Ensure appropriate PPE is used
Considered zoonotic risk
Maintain asepsis throughout sampling/collection
Locate area of interest
If required, clip the hair if it is preventing access to the area of interest
Remove curst from scabbed lesions to exposure exudate, if present
If a large amount of exudate is present, obtain a swab sample prior to and post cleaning with sterile saline or debridement
Stages of collecting a swab sample - collection
Carefully remove the swab from the package being sure not to contaminate the tip
Pre-wetting the swab with sterile saline can increase the harvest in the area of interest is dry
Roll the sterile swab (do not drag) using a consistent and controlled swabbing motion, back and forth or a zigzag pattern across the entire area of interest
Apply sufficient pressure to ensure that contact between the swab and surface is always made
Avoid necrotic as this will harbours large quantities of bacteria
Stages of collecting a swab sample - What to do once the sample has been collected
Place the swab into the sterile tube with appropriate transport media contained within the tip of the tube
Label the tube with the patient information (full name, date, area sample obtained (+/- L or R)
Correct storage of swab (process ASAP or refrigerate for no longer than 24 hours)

Stages of collecting a swab sample - Transport media and preservation and storage
Maintain viability of bacteria
Prevent reproduction
Provide essential nutrients

Transport media preservation and storage aims (swabs)
Amies media with charcoal (useful for aerobic and fastidious bacteria)
Amies without charcoal
Virus transport medium
Anaerobic transport medium

Bacteria will not survive on ..
A dry swab

Charcoal eliminates ..
Metabolic products of bacterial growth - neutralises bacterial toxins
Sample Storage and Preservation
Urine
Blood
Faeces
CSF
Synovial fluid

Sample Storage and Preservation - Urine
Boric acid preservative (refrigerate)
Specific for urine bacteriology
White power inside allows the bacteria to survive prior to analysis

Sample Storage and Preservation - Blood
Blood culture broth
Specific liquid culture
Inject blood into it (good for identification of sepsis)

Sample Storage and Preservation - Faeces
Sterile tube (refrigerate)

Sample Storage and Preservation - CSF
EDTA (do not refrigerate - very fragile)

Sample Storage and Preservation - Synovial fluid
EDTA
Sample Storage and Preservation - further considerations
Keep specimen cool to avoid bacterial growth (refrigerate at 4 ̊C) (not blood or CSF)
Follow specific guidelines set by external lab to ensure valid results achieved
Full clinical history and patient signalment should be provided to the lab
Ensure sample containers are sterile to prevent erroneous results
Aims of bacterial culture
Maintain viability of bacteria
Encourage reproduction
Inhibit the growth of unwanted microflora
Isolate individual bacteria colonies for species identification

Bacteria culture - Liquid nutrient broths
Used for bacteria that grow within the liquid, e.g. blood
Bacteria culture - Solid (jelly) nutrient solutions
Agar-based media prepared in a flat petri dush (can be used for the isolation of the individual species)
Agar alone provides no nutrition for bacterial growth. Specific nutrients and growth are impregnated into the agar base. These are designed to encourage growth of particular organisms. Isolation of individual species can only be achieved on solid media. Un-inoculated media plates should be stored within the regenerator and not frozen.
Bacterial culture - Media types
Simple media (nutrient broth, nutrient agar)
Enrichment media (blood, egg etc)
Selective/differential media (Stabourad’s agar)
Transport media - Incubate 18-24 hours at 37°C
Bacterial culture - Simple media
Provides basic nutrition for growth of nutritionally undemanding species (for example E.coli)
Examples include nutrient broth and nutrient agar
Bacterial culture - Enrichment media
Nutrient agar base with added ingredient to encourage growth of fastidious bacteria - for example, blood, egg etc
Bacteria culture - Selective/differential media
Basic nutrient agar with added nutrient to inhibit the growth of some bacteria stains, while not affecting other. Examples include Sabouraud’s agar for fungal culture (ringworm)
Bacterial culture - colonies
Colonies of bacteria will appear as round raised lumps along the streak lines
Colonies of different species may show different characteristics helpful for identification - e.g. colour, texture

Sensitivity Testing
Allows selection of the most appropriate antimicrobial
Allows the patient to be treated quickly effectively
Reduces the risks associated with antimicrobial resistance
Need a culture beforehand
Sensitivity Testing - Disc agar infusion method
A bacterial colony from loop or swab or spread over an agar plate
A manufactured disc continued a range of antibiotics is applied to the plate surface
Incubate
The resistance zone cut off is specific to each antibiotic
Accurate measurement of the zone diameter and comparison to an interpretations chart is necessary to interpret this test

Sensitivity Testing - what is the Disc agar infusion method
Most used method that determines the susceptibility of a microorganisms to a specify antimicrobial agent (efficiency, cost and convenience)
Antimicrobial agent diffuses into the solid medium from the filleter paper resulting in the inhibition of reproduction of the microorganism on its surface
A zone of inhibition form around the disc, beyond this zone an unaffected area of normal microbial growth is present
Sensitivity testing - results
Susceptible
Intermediate
Resistant
Sensitivity testing results - Susceptible
Bacterial strain is inhibited by a concentration of antibiotic that is associated with a high likelihood of threptic success
Sensitivity testing results - Intermediate
Bacterial strain inhibited by a concentration of an antibiotic that is associated with an uncertain therapeutic effect
Sensitivity testing results - Resistant
Bacterial strain is inhibited by a concentration of an antibiotic that is associated with a high likelihood of therapeutic failure